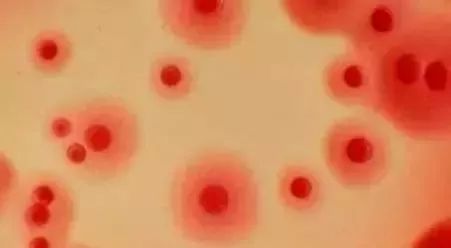
常见的眼疾病有哪些,秋冬眼病高发这几种眼病不得不防

沙眼≠沙子进了眼
沙眼是由于衣原体感染引起的一种结膜和角膜的慢性炎症性眼病,因患病后睑结膜粗糙不平形似砂粒故名沙眼。
春季是沙眼疾病爆发的季节,沙眼会给人们带来极大的危害:首先会使患者上睑下垂,感到疼痛、流泪、怕光等,时间长了还容易形成溃疡,引起沙眼性角膜炎;其次,沙眼会引起眼干、泪液不能导出湿润眼球,会使结膜、角膜发生角化性混浊肥厚;最后,沙眼长时间不治,还有导致失明的可能性。

沙眼的传染性极强,会通过毛巾、脸盆、钱、书报等物品快速传播。

沙眼怎么形成?
沙眼的形成有两种途径:一种是在多风的季节里,尘埃、细微物,最容易侵入双眼,多数人都会随意的用手揉眼睛,从而引发沙眼;而另外一种是通过手帕、毛巾等物品传染所得。
得了沙眼怎么办?
提醒:得了沙眼,千万不要用手揉

沙眼护理要点
1.沙眼患者要引起重视,按时用药,症状消失后未经医生认定,不可随便停药。
2.患者使用过的毛巾、脸盆、枕头等物品,要经常煮沸消毒或在阳光下晾晒。
3.点过眼药后,最好用酒精棉球擦手。沙眼严重、有大量滤泡者应到医院接受手术治疗。
4.养成良好的卫生习惯,勤洗手,勤剪指甲,不用手或不洁净的物品揉、擦眼部,最好用流水洗手、洗脸。消灭沙眼 预防最重要
注意用眼卫生
第一,不要经常用手揉眼睛。手接触的物品多,手上的细菌也非常多,如果动不动就要用手揉眼,很容易把致病菌带入眼睛。因此,用手抚摸眼睛之前最好洗手。
第二,不要用纸巾擦眼睛。使用纸巾擦拭眼睛,纸屑入眼后,很容易堵塞泪小管,对眼睛不利,可以用干净的手绢代替纸巾。
第三,做到一人一巾,提倡用流动水洗脸。不要借用别人的毛巾,在没有流动水的情况下,要一人一盆洗脸水。
第四,滴眼药水时,不要把眼药水的滴管接触患眼,否则细菌、微生物很容易倒吸入药瓶内,造成药水的污染。

玩过手机再揉眼增加患病率
如今,大家用眼的频率越来越高,对着电脑屏幕时间过长、玩手机刷微博发微信等,如此一来,眨眼的频次减少,泪液分泌不足,很容易诱发眼睛干涩。很多人还喜欢在公共场所玩手机、平板电脑,而公共场所的卫生状况一般比较差。由于沙眼为接触性传染病,不卫生的手触摸了电子屏幕后,再不自觉地去揉眼睛,就大大增加了感染沙眼的概率。

目前,糖尿病视网膜病变、高度近视、老年黄斑变性、青光眼、白内障等五类眼科疾病仍危害着人们的眼健康。呼吁广大群众在提高卫生用眼意识的同时,最好定期到医院做眼病的筛查,最大限度地预防和延缓致盲性眼病。
责任编辑:郭瑞芳
编。。辑:郝。璐
图文校对:李。多、王梓懿
来。。源:网。络

点击二维码
关注黑龙江省第二医院